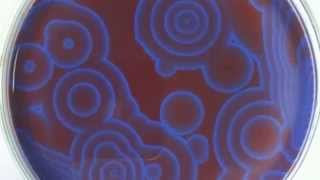
Skrillex - Fuck That

Song info
"FucK That"
(2014)
0 người yêu thích
"FucK That" Videos
Lyrics
Oh! We don't have the lyrics to this song yet.
- 0 Bản dịch
Albums has song "FucK That"

Singles
50 songs
- First Of The Year 2011
- Make It Bun Dem 2012
- Stranger (Remix With Tennyson & White Sea) 2015
- Purple Lamborghini 1 2016
- Cinema 2013
- Working For It 2015
- Breakn' A Sweat 2012
- Breathe (vocal Edit) 2012
- Goin' In 2012
- With You, Friends (Long Drive) 2013
- Seventeen 2012
- GOH 2016
- No Mercy Only Violence Remix 2011
- Breakin A Sweat 2012
- Father Said 2013
- Turn It Up 2017
- Make It Bun Them 2012
- Where Are Now 2015
- My Goodbye 2012
- Weekends!!! 2012
- To Ü 2015
- Where Are Ü Now 2015
- Ride Home 2013
- FucK That 2014
- Erase My Mind 2014
- Pop Dance 2012
- Lets Get Down 2012
- Would You Ever 2017
- Scary Monsters On Strings 2013
- Emily (Toyshop Remix) 2014
- Voltage 2012
- Lick It Down 2012
- Chicken Soup 2017
- Park Smoke 2013
- Because 2014
- Breathe 2011
- I'mma Try It Out 2012
- Bug Hunt (Noisa Remix) 2012
- Kyotov 2012
- Right Here 2011
- Smell This Money (Original Mix) 2013
- Bounce It 2016
- Ate 2013
- Baby Light Me Up 2017
- ID 2017
- Favor 2017
- Rrring 2017
- Midnight Hour (Four Tet Remix) 2019
- HUMBLE. - SKRILLEX REMIX 2018
- Pretty Bye Bye (Bad Royale Remix) 2017

Singles
46 songs
- First Of The Year 2011
- Make It Bun Dem 2012
- Stranger (Remix With Tennyson & White Sea) 2015
- Purple Lamborghini 1 2016
- Cinema 2013
- Working For It 2015
- Breathe (vocal Edit) 2012
- Goin' In 2012
- With You, Friends (Long Drive) 2013
- GOH 2016
- No Mercy Only Violence Remix 2011
- Breakin A Sweat 2012
- Father Said 2013
- Turn It Up 2017
- Make It Bun Them 2012
- Where Are Now 2015
- My Goodbye 2012
- Weekends!!! 2012
- To Ü 2015
- Where Are Ü Now 2015
- Ride Home 2013
- FucK That 2014
- Erase My Mind 2014
- Pop Dance 2012
- Lets Get Down 2012
- Would You Ever 2017
- Scary Monsters On Strings 2013
- Emily (Toyshop Remix) 2014
- Voltage 2012
- Lick It Down 2012
- Chicken Soup 2017
- Park Smoke 2013
- Because 2014
- Breathe 2011
- I'mma Try It Out 2012
- Bug Hunt (Noisa Remix) 2012
- Kyotov 2012
- Right Here 2011
- Smell This Money (Original Mix) 2013
- Bounce It 2016
- Baby Light Me Up 2017
- ID 2017
- Favor 2017
- Rrring 2017
- HUMBLE. - SKRILLEX REMIX 2018
- Pretty Bye Bye (Bad Royale Remix) 2017
![SKRILLEX - FUCK THAT [OFFICIAL VIDEO]](https://img.youtube.com/vi/Ka7wBGFSuSE/mqdefault.jpg)
![Skrillex - Fuck That [AUDIO]](https://img.youtube.com/vi/kinFrx1nRS4/mqdefault.jpg)






![Korn - Get Up! ft. Skrillex [OFFICIAL VIDEO]](https://img.youtube.com/vi/rZSh9zKeI-s/mqdefault.jpg)
![Skrillex - Fuck That [Bass Boosted]](https://img.youtube.com/vi/yTabqB7sYVc/mqdefault.jpg)




![Skrillex - Fuck That [1080p HD]](https://img.youtube.com/vi/cGBXGuN9GW8/mqdefault.jpg)

![SKRILLEX - FUCK THAT [NO FLP] [REMAKE] [AnonFace]](https://img.youtube.com/vi/x_Qh1dMQvR0/mqdefault.jpg)


Recent comments